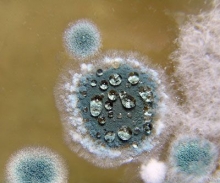

Новости
| 24.11.2012 08:08
Плесень уничтожат
В декабре 2012 года в перинатальном центре начнут применять новые технологии обеззараживания воздуха в родильных залах. «Сейчас на обработку комнаты площадью 25 квадратных метров уходит до 60 минут, - рассказывает заместитель главного врача закамской детской больницы и перинатального центра по эпидвопросам Оксана Чикина. - Не менее 2,5 часа требуется на «чистку» индивидуальных родзалов - из-за этого они нередко простаивают. С новой установкой время на обработку помещений сократится в два-три раза. За счет расширения диапазона дезинфекции, в процессе которого разрушаются не только бактерии, но и вирусы, грибы (плесень и др.).»
Последнее из рубрики Новости




